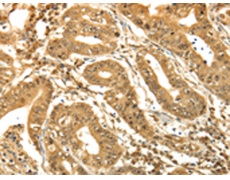
一抗

中文名稱(chēng): 兔抗RAB26多克隆抗體
英文名稱(chēng): Anti-RAB26 rabbit polyclonal antibody
相關(guān)類(lèi)別: 一抗
儲(chǔ) 存: 冷凍(-20℃)
宿 主: Rabbit
抗 原:RAB26
反應(yīng)種屬: Human, Mouse, Rat
標(biāo) 記 物: Unconjugate
克隆類(lèi)型: rabbit polyclonal
Background:
This gene encodes a small GTP-binding protein that belongs to the largest family within the Ras superfamily. RAB26 are important regulators of vesicular fusion and trafficking. The RAB family of small G proteins regulates intercellular vesicle trafficking, including exocytosis, endocytosis, and recycling.
Applications:
ELISA, WB, IHC
Name of antibody:
RAB26
Immunogen:
Synthetic peptide of human RAB26
Full name:
Ras-related protein Rab-26
SwissProt:
Q9ULW5
IHC positive control:
Human gastric cancer and human ovarian cancer
IHC Recommend dilution:
50-200
WB Predicted band size:
28 kDa
WB Positive control:
MCF7 and A375 cells
WB Recommended dilution:
200-1000
技術(shù)規(guī)格


 購(gòu)物車(chē)
購(gòu)物車(chē) 幫助
幫助
 021-54845833/15800441009
021-54845833/15800441009